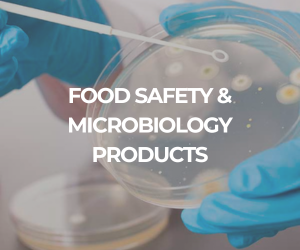

Lagos prepares for above-normal rainfall, alerts residents of possible…
By Taofeek Oyedokun The Lagos State Government has urged residents…

scientiFRIKA 2027
Africa’s Premier International Exhibition, Conference and Workshop for Industrial Science technology Solutions
Date: 25th – 27th May 2027
Venue: Nigeria
Science without Limits, Africa without Borders.
Science without Limits, Africa without Borders.
Science without Limits, Africa without Borders.
Science without Limits, Africa without Borders.
Science without Limits, Africa without Borders.
Science without Limits, Africa without Borders.
Science without Limits, Africa without Borders.
Science without Limits, Africa without Borders.
Science without Limits, Africa without Borders.
Science without Limits, Africa without Borders.
Science without Limits, Africa without Borders.
Science without Limits, Africa without Borders.
Visitors
Exhibitors
Speakers
Countries
Witness groundbreaking showcases of laboratory technologies, life science tools and diagnostic solutions from Africa and around the globe.
Participate in thought leadership sessions, workshops, and panel discussions that deepen your knowledge of science and industry applications.
Connect with key players in Manufacturing, healthcare, environmental, pharmaceuticals, agriculture, oil & gas petrochemicals, and government to foster meaningful collaborations.

scientiFRIKA 2027 + FoodsafetyAFRIKA 2027
25 – 27th May 2027
Conference Session
B2B Meetings
Brands
LIVE Stream
Enhance your experience at Africa’s International premier scientific exhibition. With the Zoho Backstage for Attendees App, you can easily access the SCIENTIFRIKA 2027 Agenda, receive instant updates from us, explore exhibitor profiles, connect with speakers and participants, and navigate the venue with confidence.
Stay organized. Stay informed. Maximize your time at SCIENTIFRIKA 2027.

Call for Abstracts Scientifrika 2027

By Taofeek Oyedokun The Lagos State Government has urged residents…
Shaking off the impact of Nigeria’s subsidy reforms, the BUA…
Nigeria forfeited between roughly $2.3bn and $3.3bn to post-harvest losses…
Nigeria is accelerating efforts to diversify its economy away from…
A Nigerian-led research team at Obafemi Awolowo University, Ile-Ife, Osun…
Companies in the shipping, logistics and manufacturing sectors see opportunities…
For More Information
Exhibition/Sponsorship Enquiries
Delegate/Speakers Enquiries
Attendee/Inquiries
Logistics Enquiries
Location
Event Venue
Lagos, Nigeria
Event Date
25th – 27th May 2027